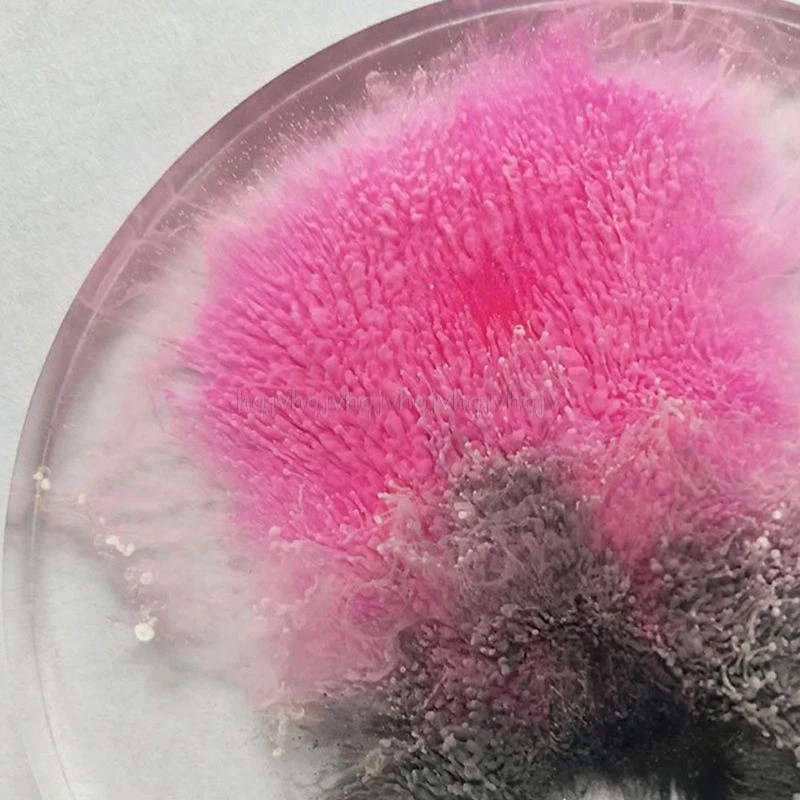

Художественные чернила натуральный пигмент краситель чернила Диффузия УФ-отверждаемая эпоксидная смола Изготовление ювелирных изделий O31 19 Прямая поставка 




163,42₽
В наличии!
HomeTool Store - Надежность 93.75%
Более 1756 подписчиков, дата открытия магазина 10.04.2018
- Положительные оценки: 95% (2483)
- Соответствие описанию: 94%
- Отвечает на сообщения: 94%
- Скорость отправки: 92%
Последнее обновление: 15.03.2022
Последнее обновление: 02.04.2022
24 цвета набор спиртовых чернил краски для рисования эпоксидная смо...
1 439,18₽
Последнее обновление: 09.03.2022
Эпоксидная смола 10 мл, пигментная жидкость краситель, чернила для ...
51,39₽
Последнее обновление: 29.05.2022
Последнее обновление: 14.04.2022
Набор художественных пигментов, набор красителей и чернил для рассе...
1 078,58₽
Последнее обновление: 04.03.2022
Последнее обновление: 15.09.2024
Художественные чернила, натуральный пигмент, краситель, диффузия че...
328,02₽
Последнее обновление: 04.03.2022
Набор спиртовых чернил для рисования, 24 цвета, чернила для эпоксид...
1 047,14₽
Последнее обновление: 02.04.2022
Оптовая продажа, художественные чернила, натуральный пигмент, краси...
138,81₽
Последнее обновление: 03.04.2022
Последнее обновление: 23.03.2022
28 цветов для рукоделия, эпоксидная смола, диффузионный пигмент, сп...
2 607,68₽
Последнее обновление: 14.03.2022
17 Цвет пигментные чернила комплект жидкость Цвет ant чернилами диф...
703,08₽
Последнее обновление: 04.05.2022
Это пигмент для рассеивания чернил, используемый на эпоксидной смоле,
С ярким цветом, легко окрашивается, стабильность цвета, яркая, чистая, гладкая текстура, водянистые жидкости и быстрый цвет,
Для нетоксичных, нераздражающих экологически чистых чернил.
Эффект разного цвета чернил-стирки в проектах смолы,
А его использование естественных волновых линий создает волшебный эффект в смоле.
Способ применения.
Капните непосредственно пигменты в смолу,
И заметьте больше смешанных цветов, больше различных волшебных эффектов в ваших проектах из смолы,
Не менее 5 разных цветов,
Белый цвет-это Базовые цвета, если вы хотите смешать больше цветов,
Из-за характеристик жидкости
Эффект каждый раз меняется,
Конечно, готовое изделие загадочное и натуральное.
Спецификация:
Тип: жидкий пигмент
Цвет: 12 цветов цвет s
-1 # белый
-2 # черный
-3 # светильник-голубой
-4 # синий
-5 # красный
-6 # розовый
-7 # желтый
-8 # оранжевый
-9 # фиолетовый
-10 # коричневый
-11 # зеленый
-12 # темно-зеленый
Размеры: 6,7х2 см/2,64 Х0, 79''
Вес нетто: 10 мл
Количество: 1 шт.
Примечание: 1. Замеры сделаны вручную, поэтому возможны отклонения на 1-3 см. Пожалуйста, убедитесь, что вы не возражаете, прежде чем делать ставку.
2. В связи с разной конфигурацией разных мониторов изображение не отображает фактический цвет товара. Спасибо!
Посылка входит (без розничной упаковки посылка:
1 пигмент смолы.

Вопросы еще не задавались...
-
Вес логистики0.040
-
Каждая упаковка1
-
Минимальная единица измерения100000015
-
Название брендаНет
-
Номер модели3906044
-
Продано Вsell_by_piece
-
ПроисхождениеКитай
-
Размер логистики - высота (см)10
-
Размер логистики - длина (см)30
-
Размер логистики - ширина (см)20























